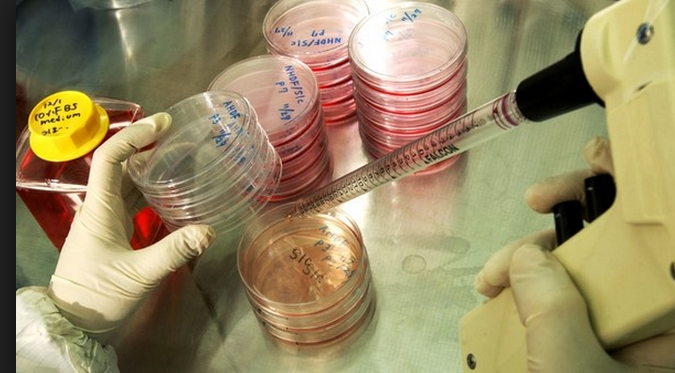

II tribunale ha autorizzato un paziente affetto da sclerosi laterale amiotrofica a sottoporsi alle cure della Stamina foundation agli Spedali civili di Brescia. E’ il secondo caso a Reggio, uno dei tanti in Italia. Ma le sentenze dei giudici non bastano per accreditare agli occhi della comunità scientifica il sedicente metodo Stamina. Michele De Luca, direttore del Centro di medicina rigenerativa “Stefano Ferrari” dell’università di Modena e Reggio, condivide il parere della grande maggioranza dei suoi colleghi, con i quali ha partecipato ieri a Roma a un convegno organizzato da Unistem, il centro interdipartimentale per la ricerca con cellule staminali: «Stamina foundation dice di avere trovato una cura efficace per più di ottomila malattie. Siamo di fronte alla più grande scoperta del secolo, degna del premio Nobel, o alla più colossale bufala, a una vera ciarlataneria». Gli esperti propendono per questa seconda ipotesi, benchè aspettino l’esito della sperimentazione per sapere la verità. «Probabilmente – asserisce De Luca – questo è un caso peggiore della terapia Di Bella (che, molto pubblicizzata, si dimostrò inefficace contro i tumori, ndr)». Non la pensano così i malati e i loro familiari, che s’aggrappano alla più esile speranza: «I pazienti – osserva De Luca – hanno tutta la mia comprensione.
Peraltro le loro associazioni hanno scritto lettere ai giornali per chiedere di essere rispettati e non essere presi in giro. Nessuno impedisce ai malati di provare qualunque trattamento. Tuttavia Stamina pretende che la sua cura sia pagata dal Servizio sanitario nazionale, che, avendo budget limitati, spesso non riesce a far fronte alle necessità». Lo scetticismo degli specialisti è avvalorato da pareri autorevolissimi: «Stamina – spiega De Luca – è stata molto brava a montare una campagna mediatica a suo favore, ma il suo metodo è stato duramente censurato dal premio Nobel Shinya Yamanaka, dalla Società internazionale per la ricerca sulle cellule staminali, dalla rivista Nature, dall’Agenzia europea del farmaco e, in Italia, dall’Accademia dei Lincei, che s’è espressa all’unanimità e per acclamazione. L’Italia ha rischato, per questa vicenda, di essere estromessa dalla comunità scientifica europea». Proprio l’università di Modena e Reggio aveva compiuto, con esito negativo, una delle prime verifiche sul metodo Stamina, già bocciato anche dall’Ufficio statunitense dei brevetti. Massimo Dominici, ricercatore di Unimore, aveva esaminato il contenuto delle ampolline contenenti il preparato che viene infuso ai pazienti, senza trovarvi neppure le cellule sottoposte a coltura. In ogni caso gli studiosi riuniti a Roma auspicano che finalmente la sperimentazione, controllata rigorosamente dall’Agenzia italiana del farmaco, faccia chiarezza sull’efficacia e sulla non nocività della terapia.

L’Associazione Luca Coscioni è una associazione no profit di promozione sociale. Tra le sue priorità vi sono l’affermazione delle libertà civili e i diritti umani, in particolare quello alla scienza, l’assistenza personale autogestita, l’abbattimento della barriere architettoniche, le scelte di fine vita, la legalizzazione dell’eutanasia, l’accesso ai cannabinoidi medici e il monitoraggio mondiale di leggi e politiche in materia di scienza e auto-determinazione.